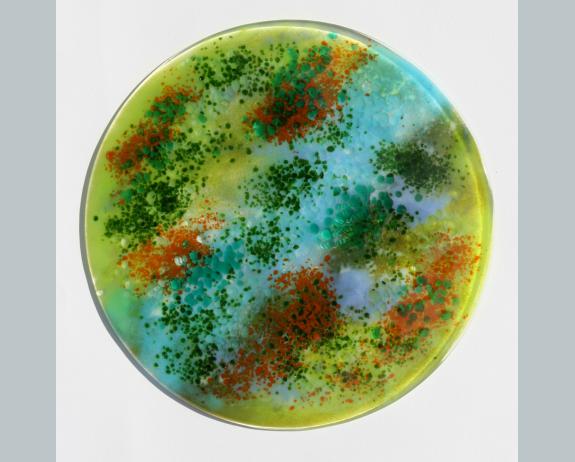

Current Exhibition
PERFECTLY PRACTICAL ( FUNCTIONAL WARE)
Glass Art that is also functional!
35 CGS members were selected to take part in this showcase of functional glass.
Thank you to all those that submitted an image of work.
The launch date for this online exhibition: 23rd May 2016.
Launched on:23rd May 2016








Artist:Roberta Mason
Email:Matthew Booth
Table Wear series..making dressing the table fun :0)
Photographer: Photo: Matthew Booth
Details: Fused glass plate and matching side bowl (B/G 30 cm plate/19 cm bowl)
Fused glass plate and matching bowl - made to look like wood with block colour design.
Perfect for crisps or crudite and dip. Intended to make dressing the table for a party fun
with the warmth and complexity of wood - but more hygenic. ;0)
Contact: roberta@bluechromis.net
Contact: roberta@bluechromis.net
TAKE PART IN NEXT EXHIBITION HEREArtist:Karen Lilley
Email:Karen Lilley
Ribbed River Bowl
Photographer: Karen Lilley
Details: A fused, gravity formed bowl, 23 cm in diameter and approximately 11 cm tall
A fused, drop-through, gravity formed bowl to be a centre piece for a dining table that could hold anything from fruit to floating flowers or candles.
Contact: Karen Lilley, email address: lilleyglassdesigns@gmail.com
Contact: lilleyglassdesigns@gmail.com
TAKE PART IN NEXT EXHIBITION HEREArtist:Brett Manley
Email:Brett Manley
Fish Bones Dish.
Photographer: Brett Manley
Details: Fused & Slumped work.
Fused and slumped long fish dish. Using handcut stencils, hand frit work and additional pre fired fused part.
Contact: info@brettmanley.co.uk
Contact: info@brettmanley.co.uk
TAKE PART IN NEXT EXHIBITION HEREArtist:Kevin Litchfield
Leaves in flight
Details: Copper inclusions
Copper leaf inclusions in slumped glass bowl 350mm diameter
Contact: Kevinlitchfield@outlook.com
Contact: Kevinlitchfield@outlook.com
TAKE PART IN NEXT EXHIBITION HEREArtist:Frances Lloyd
Email:Frances Lloyd
Rainbow fruit dish
Photographer: Photograph by Frances Lloyd
Details: 20cm square fruit dish
Made from Bullseye rods in bright, summer colours
Contact: franlloydglass@gmail.com
Contact: franlloydglass@gmail.com
TAKE PART IN NEXT EXHIBITION HEREArtist:Lynda Addison
Email:Johnny Korman
"Gone Fishing" dish for serving Sushi
Photographer: Johnny Korman
Details: Screen printed Bullseye glass, fused and slumped. 400x120x20mm. For Sale
I enjoyed playing with scale in this piece: the tiny boys gone fishing, and the monstrous fish lurking in the deep. I photographed the boat on one of our "white" summer evenings in Helsinki
Artist:Paul Mellor
Email:Paul Mellor
Hot House
Photographer: Paul Mellor
Details: Recycled glass and mirror, gravel and airplant ( Caput-Medusae)
The rigid geometric shape of the terrarium forms a cocoon,
this warms and protects yet contrasts with the natural curling
form of the airplant
Contact: p.r.mellor@btinternet.com
Contact: p.r.mellor@btinternet.com
TAKE PART IN NEXT EXHIBITION HEREArtist:Sophie Longwill
Email:Sophie Longwill
Bear bowls
Photographer: Sophie Longwill
Details: Blown hot glass
Contact: longwillsophie@gmail.com
Contact: longwillsophie@gmail.com
TAKE PART IN NEXT EXHIBITION HEREArtist:Guergana Sabkova
Illusion of Serenity
Fused glass pendant, deep carved and drill engraved to create the three-dimensional image.
www.reflexionglass.com
Contact: guery@reflexionglass.com Mob: 07960903242
Contact: guery@reflexionglass.com
TAKE PART IN NEXT EXHIBITION HEREArtist:Kevin Litchfield
Leaves in flight
Details: Copper inclusions
Copper leaf inclusions in slumped glass bowl 350mm diameter
Contact: Kevinlitchfield@outlook.com
Contact: Kevinlitchfield@outlook.com
TAKE PART IN NEXT EXHIBITION HEREArtist:Karen Grimstead
Email:Karen Grimstead
AUSPICIOUS
Photographer: Karen Grimstead
Details: Fused and slumped Bullseye glass 30cm x 30cm
A contemporary. original design inspired by Art Deco and Oriental influences. Bullseye 3mm feature glass on a transparent 3mm base, fused and slumped. Ideal serving platter for Sushi.
Contact: Karen Grimstead
Artist:JACKIE SIMMONDS
Email:JACKIE SIMMONDS
"Ocean" platter
Photographer: ? jackie simmonds
Details: fused glass platter - 11" x 11"
A fused glass piece which echoes the movement and colours of the sea. Unusually, there are spaces between the glass pieces, which gives a feeling of light and airiness.
Contact: jackiesdesk@gmail.com
Contact: jackiesdesk@gmail.com
TAKE PART IN NEXT EXHIBITION HEREArtist:Ana VIñuela
Email:Ana VIñuela
capsule lamps
Photographer: Ana VIñuela
Details: lamp1 35h/12d-30h/9d-16h/6d lamp2 30h/18d
lamp 1 three blown glass capsule made with different surface, cork base with LED light.
lamp 2 double layered uplight shade, cork base with LED light.
Contact: anavi64@yahoo.es
Contact: anavi64@yahoo.es
TAKE PART IN NEXT EXHIBITION HEREArtist:Judith Menges
Email:Judith Menges
'Mission to Mars'
Photographer: Judith Menges - Transparent Images Glass Designs
Details: 400 mm - Image of Mars with raised, tactile & sculptural surfaces
400mm - Wall hung 'Glass Art' - kiln formed glass with raised and sculptural surfaces.
The image was inspired by NASA's map of the planet. Although this is version III, each new image of the planet is different from the last, see website
www.transparentimages.com
Contact: Judith Menges 01582 460904
Contact: 01582 460904
TAKE PART IN NEXT EXHIBITION HEREArtist:Angela Muntus
Email:Angela Muntus
Fused glass platter, foraged walnuts
Photographer: Angela Muntus
Details: Fused Bullseye glass
Size 30cm square, made in 2016
Contact: Angela Muntus
Contact: Angela Muntus
TAKE PART IN NEXT EXHIBITION HEREArtist:Nicholas Collins
Email:Simon Bruntnell
ZAP Opaque Black & White Platter
Photographer: photographer Simon Bruntnell
Details: 50 cm x 50 cm x 8 cm
Zap platters are produced using cutting edge manufacturing technologies, it has taken over five hours of cutting time on a waterjet cutter to cut the individual zigzags needed to create this design, which I cut from sheets of opaque White and opaque Black glass.
Once both sheets of glass are cut, they are cleaned by hand and are laid onto a ceramic kiln shelf into the design, then the Zigzags shapes pieces are fused together at tenperatures around 800 Degree Celsius.
Once fused together the fused tile is cut and then cold worked by hand this is where the edge of the glass tile is polished to create a soft edge, then the tile is place into the kiln again over a ceramic slumping mould and fired again at a lower temperature around 650 Degree Celsius to form the piece. At this temperature it is just hot enough to soften the glass and gravity helps bend it into its funtional form following the shape of the mould.
Contact: Nicholas Collins info@nicholascollins.co.uk
Contact: info@nicholascollins.co.uk
TAKE PART IN NEXT EXHIBITION HEREArtist:Jan Langdale (formerly Taylor)
Email:Jan Taylor
'Rainbow Landscape'
Photographer: Jan Taylor
Details: Reverse glass painted splashback.
Contact: jan@janlangdale.com
Contact: jan@janlangdale.com
TAKE PART IN NEXT EXHIBITION HEREArtist:Laura Hart
Blue Kaleidoscope
Details: 400mm diameter x 100mm depth fused and kiln formed bowl.
Four complementary shades of blue fused in three offset chevron shaped layers to simulate the image created by an old style kaleidoscope.
Contact: Laura Hart - Hart Glass
Contact: Laura Hart - Hart Glass
TAKE PART IN NEXT EXHIBITION HEREArtist:Iain Smith
Email:Iain Smith
Grid Bowl
Photographer: Iain Smith
Details: Fruit Bowl 24cm dia, 5cm high
Constructed from a 3mm thick base layer of 6mm strips of black surrounding rectangles of opaline, red, orange and yellow. Capped with a 3mm layer of clear. Fused and then slumped.
Contact: Iain Smith
Contact: Iain Smith
TAKE PART IN NEXT EXHIBITION HEREArtist:Geraldine McLoughlin
Astral plate
Details: Xmas commission in Bullseye glass, frits and enamels
26cms fused x3 and slumped
Contact: 01747 870390
Contact: 01747 870390
TAKE PART IN NEXT EXHIBITION HEREArtist:Pippa Stacey
Email:Pippa Stacey
Ginko Nightlight
Photographer: Pippa Stacey
Details: Printed and draped glass
Size - 12x12x12 (approx)
Contact: pip.stacey@gmail.com
Contact: pip.stacey@gmail.com
TAKE PART IN NEXT EXHIBITION HEREView from above Padstow
Photographer: Lois Parker
Details: Kitchen splashback in six panels, total 178x33cm
Six panels depicting the view from the footpath above Padstow, looking out towards Stepper and Pentire Points and across the estuary towards Daymer Bay. The Ferry to Rock has been included (the tiny old ferry) so that the viewer can cross to the other side of the estuary.
Contact: Loisparkerglass@gmail.com
Contact: Loisparkerglass@gmail.com
TAKE PART IN NEXT EXHIBITION HEREArtist:Dina Priess dos Santos
Email:Dina Priess dos Santos
perfectly practical
Photographer: Dina Priess dos Santos
Details: freeze and sand cast pate de verre, life size
Contact: dinadossantos09@gmail.com
Contact: dinadossantos09@gmail.com
TAKE PART IN NEXT EXHIBITION HEREArtist:Jenia gorfunkel
Email:Jenia gorfunkel
Pyramid Lamp
Photographer: Jenia Gorfunkel
Details: Table top lamp in the shape of a three-sided pyramid.
This lamp is made from fused bottle glass and is put together using Tiffany technique.
Contact: jgorfunkel@hotmail.com
Contact: jgorfunkel@hotmail.com
TAKE PART IN NEXT EXHIBITION HEREArtist:E John Lewis
Email:E John Lewis
Primary & Secondary Abstract
Photographer: E John Lewis
Details: Side panels each approximately 800mm x 2000mm, double glazed units.
Neutral coloured sandblast layers, with complimentary coloured glass bonded within the units.
Contact: info@ejlewis-glass.com
Contact: info@ejlewis-glass.com
TAKE PART IN NEXT EXHIBITION HEREArtist:Richie Alli
Email:Clash&Clash
Crystal Lamp
Photographer: Clash&Clash Photography
Details: 33x14x14cm
Handblown, ground and polished lead crystal lamp
Contact: 07999406231
Contact: 07999406231
TAKE PART IN NEXT EXHIBITION HEREArtist:Dominic Fonde
Email:Dominic Fonde
Get out while you can
Photographer: Dominic Fonde
Details: Short story written by Dominic Fonde and drill engraved on a mass produced wine glass.
In the half-light of the restaurant she sipped her wine and thought, “I am having so much fun”.
They had met via a dating website and despite her trepidation she had to admit that it was all going fine. He was charming, polite, and attentive and although a few years older than the picture he’d posted online, definitely fell into the ranks of the handsome.
He excused himself and headed towards the men’s room. She beckoned the waiter and had their wine glasses refilled.
“Are you ready to order?” he asked mechanically. She had not even looked at the menu yet. This was probably a good moment to get some ideas, especially as she had never visited this place before.
“Any recommendations?” she asked playfully.
“Get out while you can” the waiter told her “You’re his third date this week”.
Contact: dominicfondeglass@gmail.com
Contact: dominicfondeglass@gmail.com
TAKE PART IN NEXT EXHIBITION HEREArtist:David Frazer
Aqua pattern bar plate
Details: 27x27cm Spectrum glass & a bit of copper oxide
Artist:Teresa Chlapowski
Email:Ester Segarra
Fiesta Cushion Bowl
Photographer: Ester Segarra
Details: Fused and slumped float glass 34 x 36 x 8 cm
a very fluid form, with 'pockets' that can be used for dips, fruit or something different in each hollow!
Contact: aquarelledesign@chlapowski.plus.com
Contact: aquarelledesign@chlapowski.plus.com
TAKE PART IN NEXT EXHIBITION HEREArtist:Susan Sinclair
Email:Susan Sinclair
Chroma I Series
Photographer: Susan Sinclair
Details: A vessel series building upon use of analogous colours
Deep vessels made from analogous colours of glass sheet, kiln-formed, each 150mm high x 75mm diameter; mint, orange, teal, canary and cyan
Contact: www.churchhouseart.co.uk
Contact: www.churchhouseart.co.uk
TAKE PART IN NEXT EXHIBITION HEREArtist:Mike barrett
Email:Mike barrett
Cha Wan
Photographer: Mike barrett
Details: Red & black bullseye cha wan
Integral core cast cha wan from a hand carved clay master
Contact: 07803 887464
Contact: 07803 887464
TAKE PART IN NEXT EXHIBITION HEREArtist:Anne Somers
Email:Anne Somers
Fused Glass Lamp of Ingleborough
Photographer: Anne Somers
Details: Fused glass mounted on wood with light fitting.
Glass panel depicting Ingleborough, a favourite hill walk for locals and tourists with its distinctive outline, the panel measures approx 24cm x 30cm, mounted on a wooden base with an electric light fitting fixed to the base.
Contact: Arkglass@btinternet.com
Contact: Arkglass@btinternet.com
TAKE PART IN NEXT EXHIBITION HEREArtist:Jill Bagnall
Email:Simon Bruntnell
Blue Waves
Photographer: Photograph by Simon Bruntnell
Details: A shallow fruit or serving dish in periwinkle blue with 'floating' pattern bar chip inclusions
This fabulously functional dish is approximately 30cm by 20cm. It has a soft wavey edge which is irresistibly tactile. Great displayed; designed to be used.
Contact: Jill Bagnall 07941 232218
Contact: 07941 232218
TAKE PART IN NEXT EXHIBITION HEREArtist:Hannah Gibson
Fused Glass Weave Plate
Photographer: Hannah Gibson
Details: 26cm x 26cm
Made using Bullseye Glass
Contact: hannah@lemonpeach.com
Contact: hannah@lemonpeach.com
TAKE PART IN NEXT EXHIBITION HEREArtist:Beth Tierney
Email:Beth Tierney
The Willows, fused glass house sign
Photographer: Beth Tierney, See through sand
Details: Bullseye glass with copper, 30 cm wide x 20 cm high
This sign was created to direct people to a "hidden" front door. It uses a cream Bullseye glass background with an art deco inspired font in copper. The decorative elements are in natural tones to compliment the woodwork and surrounding stone walls.
Contact: contact@seethroughsand.uk
Contact: contact@seethroughsand.uk
TAKE PART IN NEXT EXHIBITION HEREArtist:Anthony McCabe
Email:Anthony McCabe
Twist neck vase
Photographer: Photography: Anthony McCabe
Details: Twisted neck blown form in clear glass with sprinkle of enamel colour in the base.
Twisted neck blown form in clear glass with sprinkle of enamel colour in the base.
Contact: Anthony McCabe
















_0.jpg)

Artist:Roberta Mason
Email:Matthew Booth
Table Wear series..making dressing the table fun :0)
Photographer: Photo: Matthew Booth
Details: Fused glass plate and matching side bowl (B/G 30 cm plate/19 cm bowl)
Fused glass plate and matching bowl - made to look like wood with block colour design.
Perfect for crisps or crudite and dip. Intended to make dressing the table for a party fun
with the warmth and complexity of wood - but more hygenic. ;0)
Contact: roberta@bluechromis.net
Contact: roberta@bluechromis.net
TAKE PART IN NEXT EXHIBITION HEREArtist:Karen Lilley
Email:Karen Lilley
Ribbed River Bowl
Photographer: Karen Lilley
Details: A fused, gravity formed bowl, 23 cm in diameter and approximately 11 cm tall
A fused, drop-through, gravity formed bowl to be a centre piece for a dining table that could hold anything from fruit to floating flowers or candles.
Contact: Karen Lilley, email address: lilleyglassdesigns@gmail.com
Contact: lilleyglassdesigns@gmail.com
TAKE PART IN NEXT EXHIBITION HEREArtist:Brett Manley
Email:Brett Manley
Fish Bones Dish.
Photographer: Brett Manley
Details: Fused & Slumped work.
Fused and slumped long fish dish. Using handcut stencils, hand frit work and additional pre fired fused part.
Contact: info@brettmanley.co.uk
Contact: info@brettmanley.co.uk
TAKE PART IN NEXT EXHIBITION HEREArtist:Kevin Litchfield
Leaves in flight
Details: Copper inclusions
Copper leaf inclusions in slumped glass bowl 350mm diameter
Contact: Kevinlitchfield@outlook.com
Contact: Kevinlitchfield@outlook.com
TAKE PART IN NEXT EXHIBITION HEREArtist:Frances Lloyd
Email:Frances Lloyd
Rainbow fruit dish
Photographer: Photograph by Frances Lloyd
Details: 20cm square fruit dish
Made from Bullseye rods in bright, summer colours
Contact: franlloydglass@gmail.com
Contact: franlloydglass@gmail.com
TAKE PART IN NEXT EXHIBITION HEREArtist:Lynda Addison
Email:Johnny Korman
"Gone Fishing" dish for serving Sushi
Photographer: Johnny Korman
Details: Screen printed Bullseye glass, fused and slumped. 400x120x20mm. For Sale
I enjoyed playing with scale in this piece: the tiny boys gone fishing, and the monstrous fish lurking in the deep. I photographed the boat on one of our "white" summer evenings in Helsinki
Artist:Paul Mellor
Email:Paul Mellor
Hot House
Photographer: Paul Mellor
Details: Recycled glass and mirror, gravel and airplant ( Caput-Medusae)
The rigid geometric shape of the terrarium forms a cocoon,
this warms and protects yet contrasts with the natural curling
form of the airplant
Contact: p.r.mellor@btinternet.com
Contact: p.r.mellor@btinternet.com
TAKE PART IN NEXT EXHIBITION HEREArtist:Sophie Longwill
Email:Sophie Longwill
Bear bowls
Photographer: Sophie Longwill
Details: Blown hot glass
Contact: longwillsophie@gmail.com
Contact: longwillsophie@gmail.com
TAKE PART IN NEXT EXHIBITION HEREArtist:Guergana Sabkova
Illusion of Serenity
Fused glass pendant, deep carved and drill engraved to create the three-dimensional image.
www.reflexionglass.com
Contact: guery@reflexionglass.com Mob: 07960903242
Contact: guery@reflexionglass.com
TAKE PART IN NEXT EXHIBITION HEREArtist:Kevin Litchfield
Leaves in flight
Details: Copper inclusions
Copper leaf inclusions in slumped glass bowl 350mm diameter
Contact: Kevinlitchfield@outlook.com
Contact: Kevinlitchfield@outlook.com
TAKE PART IN NEXT EXHIBITION HEREArtist:Karen Grimstead
Email:Karen Grimstead
AUSPICIOUS
Photographer: Karen Grimstead
Details: Fused and slumped Bullseye glass 30cm x 30cm
A contemporary. original design inspired by Art Deco and Oriental influences. Bullseye 3mm feature glass on a transparent 3mm base, fused and slumped. Ideal serving platter for Sushi.
Contact: Karen Grimstead
Artist:JACKIE SIMMONDS
Email:JACKIE SIMMONDS
"Ocean" platter
Photographer: ? jackie simmonds
Details: fused glass platter - 11" x 11"
A fused glass piece which echoes the movement and colours of the sea. Unusually, there are spaces between the glass pieces, which gives a feeling of light and airiness.
Contact: jackiesdesk@gmail.com
Contact: jackiesdesk@gmail.com
TAKE PART IN NEXT EXHIBITION HEREArtist:Ana VIñuela
Email:Ana VIñuela
capsule lamps
Photographer: Ana VIñuela
Details: lamp1 35h/12d-30h/9d-16h/6d lamp2 30h/18d
lamp 1 three blown glass capsule made with different surface, cork base with LED light.
lamp 2 double layered uplight shade, cork base with LED light.
Contact: anavi64@yahoo.es
Contact: anavi64@yahoo.es
TAKE PART IN NEXT EXHIBITION HEREArtist:Judith Menges
Email:Judith Menges
'Mission to Mars'
Photographer: Judith Menges - Transparent Images Glass Designs
Details: 400 mm - Image of Mars with raised, tactile & sculptural surfaces
400mm - Wall hung 'Glass Art' - kiln formed glass with raised and sculptural surfaces.
The image was inspired by NASA's map of the planet. Although this is version III, each new image of the planet is different from the last, see website
www.transparentimages.com
Contact: Judith Menges 01582 460904
Contact: 01582 460904
TAKE PART IN NEXT EXHIBITION HEREArtist:Angela Muntus
Email:Angela Muntus
Fused glass platter, foraged walnuts
Photographer: Angela Muntus
Details: Fused Bullseye glass
Size 30cm square, made in 2016
Contact: Angela Muntus
Contact: Angela Muntus
TAKE PART IN NEXT EXHIBITION HEREArtist:Nicholas Collins
Email:Simon Bruntnell
ZAP Opaque Black & White Platter
Photographer: photographer Simon Bruntnell
Details: 50 cm x 50 cm x 8 cm
Zap platters are produced using cutting edge manufacturing technologies, it has taken over five hours of cutting time on a waterjet cutter to cut the individual zigzags needed to create this design, which I cut from sheets of opaque White and opaque Black glass.
Once both sheets of glass are cut, they are cleaned by hand and are laid onto a ceramic kiln shelf into the design, then the Zigzags shapes pieces are fused together at tenperatures around 800 Degree Celsius.
Once fused together the fused tile is cut and then cold worked by hand this is where the edge of the glass tile is polished to create a soft edge, then the tile is place into the kiln again over a ceramic slumping mould and fired again at a lower temperature around 650 Degree Celsius to form the piece. At this temperature it is just hot enough to soften the glass and gravity helps bend it into its funtional form following the shape of the mould.
Contact: Nicholas Collins info@nicholascollins.co.uk
Contact: info@nicholascollins.co.uk
TAKE PART IN NEXT EXHIBITION HEREArtist:Jan Langdale (formerly Taylor)
Email:Jan Taylor
'Rainbow Landscape'
Photographer: Jan Taylor
Details: Reverse glass painted splashback.
Contact: jan@janlangdale.com
Contact: jan@janlangdale.com
TAKE PART IN NEXT EXHIBITION HEREArtist:Laura Hart
Blue Kaleidoscope
Details: 400mm diameter x 100mm depth fused and kiln formed bowl.
Four complementary shades of blue fused in three offset chevron shaped layers to simulate the image created by an old style kaleidoscope.
Contact: Laura Hart - Hart Glass
Contact: Laura Hart - Hart Glass
TAKE PART IN NEXT EXHIBITION HEREArtist:Iain Smith
Email:Iain Smith
Grid Bowl
Photographer: Iain Smith
Details: Fruit Bowl 24cm dia, 5cm high
Constructed from a 3mm thick base layer of 6mm strips of black surrounding rectangles of opaline, red, orange and yellow. Capped with a 3mm layer of clear. Fused and then slumped.
Contact: Iain Smith
Contact: Iain Smith
TAKE PART IN NEXT EXHIBITION HEREArtist:Geraldine McLoughlin
Astral plate
Details: Xmas commission in Bullseye glass, frits and enamels
26cms fused x3 and slumped
Contact: 01747 870390
Contact: 01747 870390
TAKE PART IN NEXT EXHIBITION HEREArtist:Pippa Stacey
Email:Pippa Stacey
Ginko Nightlight
Photographer: Pippa Stacey
Details: Printed and draped glass
Size - 12x12x12 (approx)
Contact: pip.stacey@gmail.com
Contact: pip.stacey@gmail.com
TAKE PART IN NEXT EXHIBITION HEREView from above Padstow
Photographer: Lois Parker
Details: Kitchen splashback in six panels, total 178x33cm
Six panels depicting the view from the footpath above Padstow, looking out towards Stepper and Pentire Points and across the estuary towards Daymer Bay. The Ferry to Rock has been included (the tiny old ferry) so that the viewer can cross to the other side of the estuary.
Contact: Loisparkerglass@gmail.com
Contact: Loisparkerglass@gmail.com
TAKE PART IN NEXT EXHIBITION HEREArtist:Dina Priess dos Santos
Email:Dina Priess dos Santos
perfectly practical
Photographer: Dina Priess dos Santos
Details: freeze and sand cast pate de verre, life size
Contact: dinadossantos09@gmail.com
Contact: dinadossantos09@gmail.com
TAKE PART IN NEXT EXHIBITION HEREArtist:Jenia gorfunkel
Email:Jenia gorfunkel
Pyramid Lamp
Photographer: Jenia Gorfunkel
Details: Table top lamp in the shape of a three-sided pyramid.
This lamp is made from fused bottle glass and is put together using Tiffany technique.
Contact: jgorfunkel@hotmail.com
Contact: jgorfunkel@hotmail.com
TAKE PART IN NEXT EXHIBITION HEREArtist:E John Lewis
Email:E John Lewis
Primary & Secondary Abstract
Photographer: E John Lewis
Details: Side panels each approximately 800mm x 2000mm, double glazed units.
Neutral coloured sandblast layers, with complimentary coloured glass bonded within the units.
Contact: info@ejlewis-glass.com
Contact: info@ejlewis-glass.com
TAKE PART IN NEXT EXHIBITION HEREArtist:Richie Alli
Email:Clash&Clash
Crystal Lamp
Photographer: Clash&Clash Photography
Details: 33x14x14cm
Handblown, ground and polished lead crystal lamp
Contact: 07999406231
Contact: 07999406231
TAKE PART IN NEXT EXHIBITION HEREArtist:Dominic Fonde
Email:Dominic Fonde
Get out while you can
Photographer: Dominic Fonde
Details: Short story written by Dominic Fonde and drill engraved on a mass produced wine glass.
In the half-light of the restaurant she sipped her wine and thought, “I am having so much fun”.
They had met via a dating website and despite her trepidation she had to admit that it was all going fine. He was charming, polite, and attentive and although a few years older than the picture he’d posted online, definitely fell into the ranks of the handsome.
He excused himself and headed towards the men’s room. She beckoned the waiter and had their wine glasses refilled.
“Are you ready to order?” he asked mechanically. She had not even looked at the menu yet. This was probably a good moment to get some ideas, especially as she had never visited this place before.
“Any recommendations?” she asked playfully.
“Get out while you can” the waiter told her “You’re his third date this week”.
Contact: dominicfondeglass@gmail.com
Contact: dominicfondeglass@gmail.com
TAKE PART IN NEXT EXHIBITION HEREArtist:David Frazer
Aqua pattern bar plate
Details: 27x27cm Spectrum glass & a bit of copper oxide
Artist:Teresa Chlapowski
Email:Ester Segarra
Fiesta Cushion Bowl
Photographer: Ester Segarra
Details: Fused and slumped float glass 34 x 36 x 8 cm
a very fluid form, with 'pockets' that can be used for dips, fruit or something different in each hollow!
Contact: aquarelledesign@chlapowski.plus.com
Contact: aquarelledesign@chlapowski.plus.com
TAKE PART IN NEXT EXHIBITION HEREArtist:Susan Sinclair
Email:Susan Sinclair
Chroma I Series
Photographer: Susan Sinclair
Details: A vessel series building upon use of analogous colours
Deep vessels made from analogous colours of glass sheet, kiln-formed, each 150mm high x 75mm diameter; mint, orange, teal, canary and cyan
Contact: www.churchhouseart.co.uk
Contact: www.churchhouseart.co.uk
TAKE PART IN NEXT EXHIBITION HEREArtist:Mike barrett
Email:Mike barrett
Cha Wan
Photographer: Mike barrett
Details: Red & black bullseye cha wan
Integral core cast cha wan from a hand carved clay master
Contact: 07803 887464
Contact: 07803 887464
TAKE PART IN NEXT EXHIBITION HEREArtist:Anne Somers
Email:Anne Somers
Fused Glass Lamp of Ingleborough
Photographer: Anne Somers
Details: Fused glass mounted on wood with light fitting.
Glass panel depicting Ingleborough, a favourite hill walk for locals and tourists with its distinctive outline, the panel measures approx 24cm x 30cm, mounted on a wooden base with an electric light fitting fixed to the base.
Contact: Arkglass@btinternet.com
Contact: Arkglass@btinternet.com
TAKE PART IN NEXT EXHIBITION HEREArtist:Jill Bagnall
Email:Simon Bruntnell
Blue Waves
Photographer: Photograph by Simon Bruntnell
Details: A shallow fruit or serving dish in periwinkle blue with 'floating' pattern bar chip inclusions
This fabulously functional dish is approximately 30cm by 20cm. It has a soft wavey edge which is irresistibly tactile. Great displayed; designed to be used.
Contact: Jill Bagnall 07941 232218
Contact: 07941 232218
TAKE PART IN NEXT EXHIBITION HEREArtist:Hannah Gibson
Fused Glass Weave Plate
Photographer: Hannah Gibson
Details: 26cm x 26cm
Made using Bullseye Glass
Contact: hannah@lemonpeach.com
Contact: hannah@lemonpeach.com
TAKE PART IN NEXT EXHIBITION HEREArtist:Beth Tierney
Email:Beth Tierney
The Willows, fused glass house sign
Photographer: Beth Tierney, See through sand
Details: Bullseye glass with copper, 30 cm wide x 20 cm high
This sign was created to direct people to a "hidden" front door. It uses a cream Bullseye glass background with an art deco inspired font in copper. The decorative elements are in natural tones to compliment the woodwork and surrounding stone walls.
Contact: contact@seethroughsand.uk
Contact: contact@seethroughsand.uk
TAKE PART IN NEXT EXHIBITION HEREArtist:Anthony McCabe
Email:Anthony McCabe
Twist neck vase
Photographer: Photography: Anthony McCabe
Details: Twisted neck blown form in clear glass with sprinkle of enamel colour in the base.
Twisted neck blown form in clear glass with sprinkle of enamel colour in the base.
Contact: Anthony McCabe

